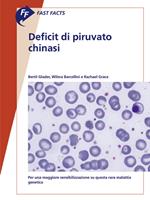

IBS.it, l'altro eCommerce
L’articolo è stato aggiunto alla lista dei desideri
Ebook S. Karger
Filtri (1)
S. karger

Reparti
Disponibilità
Prezzo (€)
Autori
Vedi tutti
Mostra meno
Venditore
Tutti i risultati (12)
Fast Facts: Ottimizzazione del trattamento delle fluttuazioni motorie nella malattia di Parkinson
Venditore: IBS
Omaggio
Fast Facts: Ottimizzazione del trattamento delle fluttuazioni motorie nella malattia di Parkinson
Venditore: IBS
Omaggio
Informazioni sull’ordinamento
Vengono mostrati per primi i prodotti che rispondono a questi criteri: rilevanza rispetto alla ricerca, dati di venduto, disponibilità, data di pubblicazione, tipologia di prodotto, personalizzazione ad eccezione delle sponsorizzazioni.